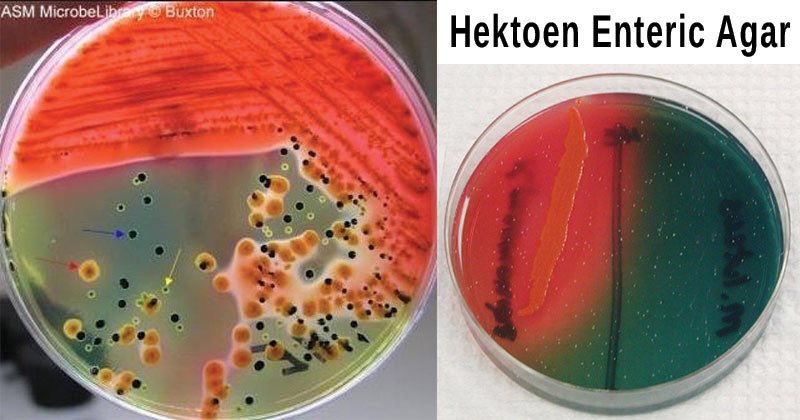
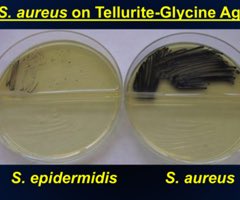

Blood Agar 1️⃣
يعتبر Enriched و Differential
⭕️المبدأ:
البكتيريا تفرز hemolysins اللي راح يدمرRBC ويتم التفريق بين بكتيريا وأخرى عن طريق قدرة البكتيريا على تدمير RBCs
يعتبر Enriched و Differential
⭕️المبدأ:
البكتيريا تفرز hemolysins اللي راح يدمرRBC ويتم التفريق بين بكتيريا وأخرى عن طريق قدرة البكتيريا على تدمير RBCs
MacConKey (MAC) 3️⃣
يعتبر Selective و Differential
ويستخدم في التفريق بين انواع Enterobacteriaceae
يحتوي على:
▪️Bile salt, Crystal violet اللي يمنع من نمو لجرام موجب بكتيريا
▪️neutral red dye هذا مقياس pH في الاجار
اقل عن 6.8 ⬅️ احمر
واذا اكبر ⬅️ لا يتغير لون
يعتبر Selective و Differential
ويستخدم في التفريق بين انواع Enterobacteriaceae
يحتوي على:
▪️Bile salt, Crystal violet اللي يمنع من نمو لجرام موجب بكتيريا
▪️neutral red dye هذا مقياس pH في الاجار
اقل عن 6.8 ⬅️ احمر
واذا اكبر ⬅️ لا يتغير لون
4️⃣ Eosin Methylene Blue agar (EMB)
يعتبر Selective و Differential
ويستخدم لعزل البكتيريا القولونية البرازية
(fecal coliforms)
يعتبر Selective و Differential
ويستخدم لعزل البكتيريا القولونية البرازية
(fecal coliforms)
Desoxycholate agar (DOC) 5️⃣
يعتبر Selective و Differential
يستخدم لعزل وتفريق بين Enterobacteriaceae و تحديد coliform
يحيتوي على:
▪️lactose اللي يسمح بتفرقه
▪️sodium desoxycholate يمنع نمو لجرام موجب
▪️neutral red dye كاشف لل pH
اقل من 6.8 ⬅️ شفاف
اكبر من 6.8 ⬅️ احمر
يعتبر Selective و Differential
يستخدم لعزل وتفريق بين Enterobacteriaceae و تحديد coliform
يحيتوي على:
▪️lactose اللي يسمح بتفرقه
▪️sodium desoxycholate يمنع نمو لجرام موجب
▪️neutral red dye كاشف لل pH
اقل من 6.8 ⬅️ شفاف
اكبر من 6.8 ⬅️ احمر
mannitol salt agar (MSA) 6️⃣
يعتبر Selective و Differential
ويستخدم لعزل Staphylococcus aureus من باقي Staphylococci spp
يعتبر Selective و Differential
ويستخدم لعزل Staphylococcus aureus من باقي Staphylococci spp
7️⃣ Xylose lysine desoxycholate agar (XLD)
يعتبر Selective و Differential
يستخدم لعزل وتفريق بين
salmonella and shigella
يعتبر Selective و Differential
يستخدم لعزل وتفريق بين
salmonella and shigella
8️⃣ Salmonella-Shigella agar (SS)
يعتبر Selective و Differential
يستخدم لعزل وتفريق بين salmonella and shigella
يحتوي على:
▪️lactose اللي يسمح بتفرقه
▪️bile salts و brilliant green dye يثبط نمو جرام موجب و بعض جرام سالب
يعتبر Selective و Differential
يستخدم لعزل وتفريق بين salmonella and shigella
يحتوي على:
▪️lactose اللي يسمح بتفرقه
▪️bile salts و brilliant green dye يثبط نمو جرام موجب و بعض جرام سالب
1️⃣1️⃣ thiosulfate citrate bile sucrose agar (TCBS)
يعتبر Selective و Differential
يستخدم لعزل vibrio spp
يحتوي على
▪️oxtall و sodium cholate يمنع نمو جرام موجب
▪️sucrose اللي يسمح بتفرقه
▪️sodium thiosulfate
▪️bromthymol blue كاشف لل pH
▪️ferric citrate يتفاعل مع H2S ⬅️ترسبات
يعتبر Selective و Differential
يستخدم لعزل vibrio spp
يحتوي على
▪️oxtall و sodium cholate يمنع نمو جرام موجب
▪️sucrose اللي يسمح بتفرقه
▪️sodium thiosulfate
▪️bromthymol blue كاشف لل pH
▪️ferric citrate يتفاعل مع H2S ⬅️ترسبات
جاري تحميل الاقتراحات...